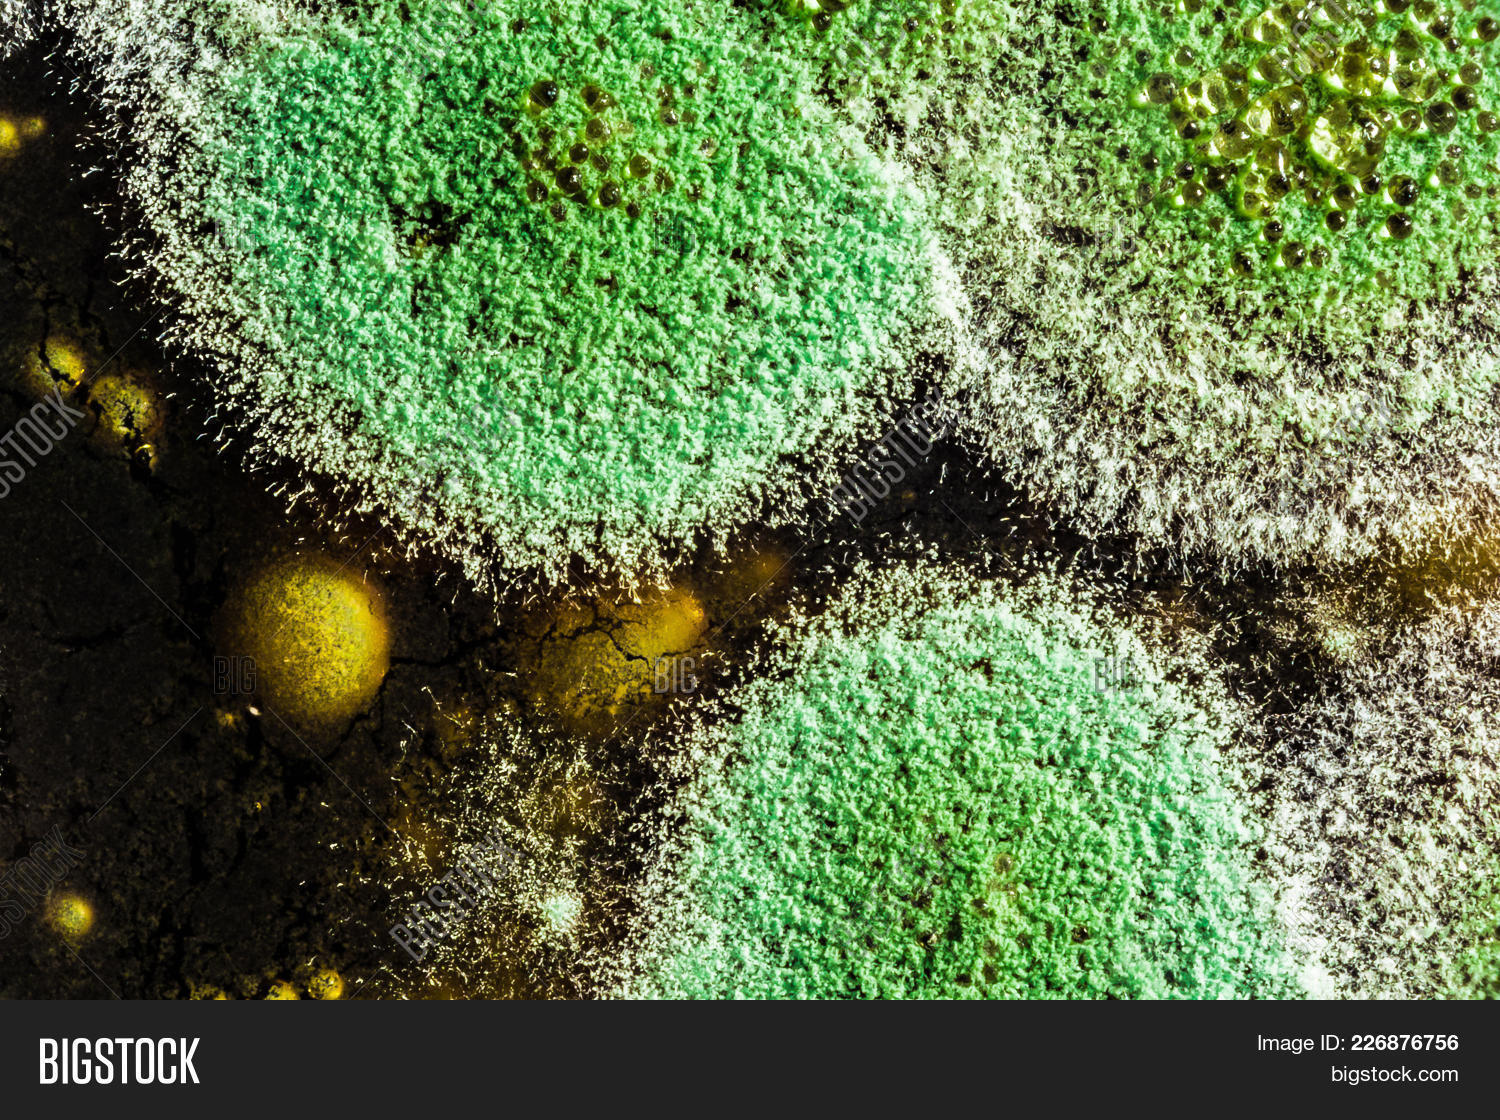
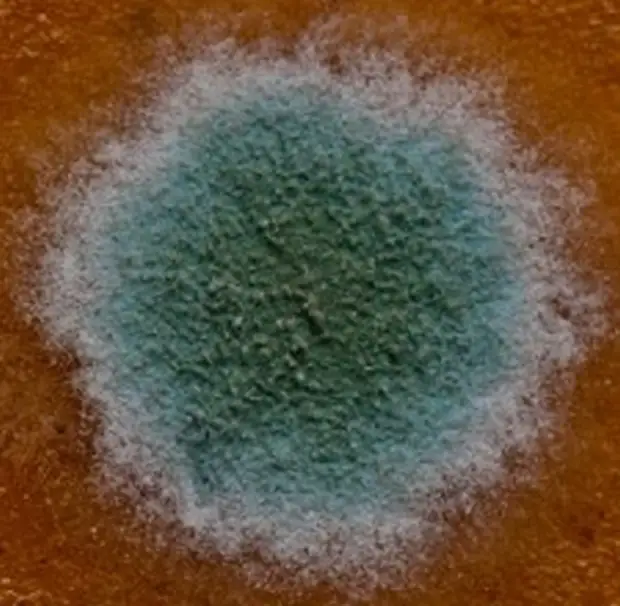

Зеленая плесень уже покрыла
Eşref rüya 2 bölüm full izle
Шутить д
Эпидемия фентанила в сша
Какое тесто брать на пиццу
Проверочная работа по теме великая французская революция
Фарш к спагетти рецепт
Как помогает правильное питание
Control игра сектора
Зачем тебе я минусовка
Я бросаю миру вызов на глазах песня
Тпмпк екатеринбург
Тг рерум новарум
Планшет blackview tab 60 6 128gb
Зеленая плесень уже покрыла 109 фото